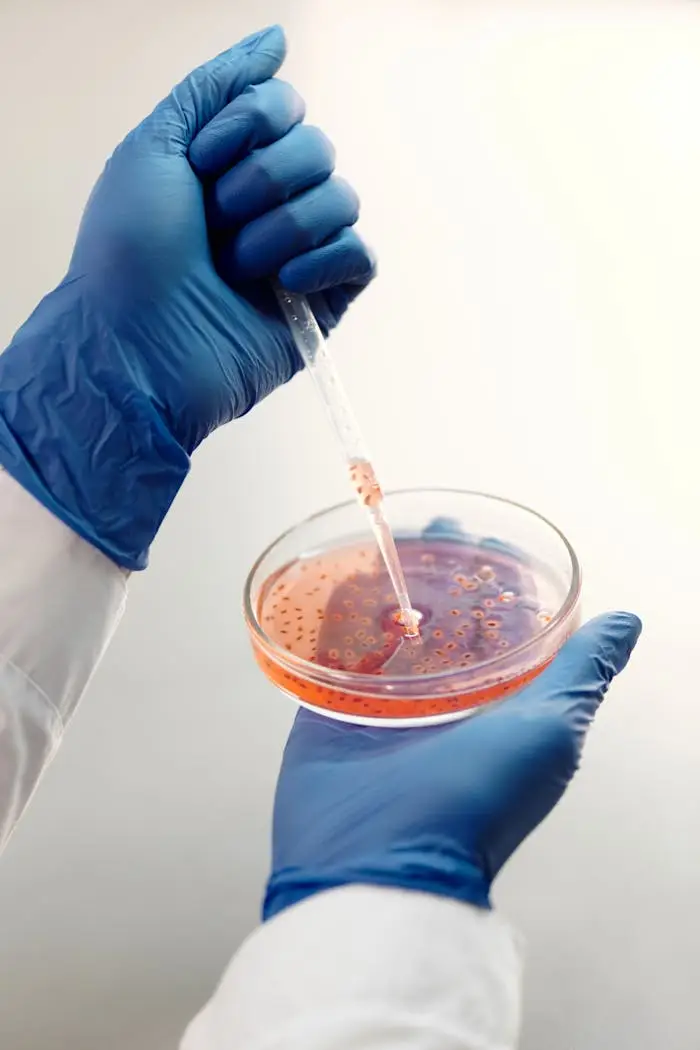

Proyectos destacados en Farmantastic
Descubre nuestro portafolio, donde compartimos los proyectos más relevantes y las contribuciones innovadoras de los profesionales sanitarios para mejorar la atención médica y la salud pública en nuestra comunidad.
Novedades Sanitarias





Farmantastic es un recurso invaluable para mí. Encuentro información relevante y actualizada que mejora mi práctica profesional diariamente.
Recursos Educativos






La plataforma me ayuda a estar al tanto de novedades que realmente importan en el ámbito de la sanidad. ¡Altamente recomendada!
Avances Científicos

Desde que uso Farmantastic, he aprendido a integrar conocimientos de otras especialidades que mejoran mi atención al paciente. Es una herramienta esencial.







